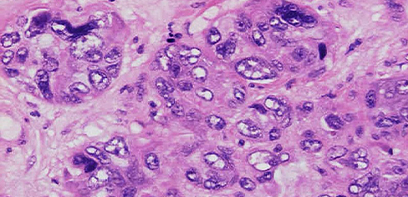

Expert insight: Better access to dental care may have potential benefits beyond Canadians’ mouths
December 22, 2023

In an article for The Conversation, Dr. Noha Gomaa writes that access to dental care will enhance Canadians’ oral health and potentially help in managing chronic diseases.
Announcement: Dr. Patricia Hall re-appointed as interim Chair of the Department of Psychiatry
December 20, 2023

I am pleased to announce that the appointment of Dr. Patricia Hall as interim Chair of the Department of Psychiatry, Schulich School of Medicine & Dentistry, Western University, has been extended effective January 15, 2024 to December 31, 2024 or until a permanent Chair is appointed.
Announcement: Dr. John Fuller re-appointed as interim Chair, Department of Anesthesia & Perioperative Medicine
December 20, 2023

I am pleased to announce that the appointment of Dr. John Fuller as interim Chair, Department of Anesthesia & Perioperative Medicine, Schulich School of Medicine & Dentistry, Western University, has been extended effective January 1, 2024 to February 28, 2024 or until a permanent Chair is appointed.
New study sheds light on connection between microbiome and kidney stones
December 20, 2023

A new study has found changes in the microbiome in multiple locations in the body are linked to the formation of kidney stones. The research team examined bacteria in the gut, urinary tract and mouth.
Nicole Redvers brings Indigenous perspectives to WHO advisory group appointment
December 19, 2023

Nicole Redvers, ND, MPH, has been appointed to the World Health Organization’s Technical Advisory Group on Embedding Ethics in Health and Climate Change Policy. As one of 13 members, she will help deliver a range of tools, materials and evidence-based insights to address this worldwide challenge.
Donation of $8.5 million strengthens hearing science and innovation
December 18, 2023

Transforming care for patients with hearing loss is the focus of a donation from global hearing implant company MED-EL.
Announcement: Dr. David A. Steven re-appointed chair Department of Clinical Neurological Sciences
December 18, 2023

We are pleased to announce that Dr. David A. Steven has been re-appointed to the Department of Clinical Neurological Sciences as Chair (Schulich School of Medicine & Dentistry, Western University), Physician Department Executive (London Health Sciences Centre) and Chief (St. Joseph’s Health Care London). The re-appointment will be effective January 1, 2024, to December 31, 2028.
A look back at the top stories of 2023
December 13, 2023

Schulich Medicine & Dentistry experts brought their research expertise, innovative thinking and thought leadership to bear on some of the most pervasive health challenges facing the world in 2023. Read about the important contributions made by our people as told through some of the year's top stories.
Students offer support, mentorship to medical and dental school applicants
December 13, 2023

Founded by medical students, ACCESS Inc. aims to make the admissions process more equitable for under-represented students applying to the Doctor of Medicine and Doctor of Dental Surgery programs at Schulich Medicine & Dentistry.
Announcement: Dr. Sumit Agrawal has been re-appointed to the Department of Otolaryngology as Interim Chair
December 08, 2023

We are pleased to announce that Dr. Sumit Agrawal has been re-appointed to the Department of Otolaryngology as Interim Chair (Schulich School of Medicine & Dentistry, Western University), Interim Physician Department Executive (London Health Sciences Centre) and Interim Chief (St. Joseph’s Health Care London). The re-appointment will be effective January 1, 2024, to December 31, 2024, or until a permanent PDE/Chair/Chief is appointed.
Research shows impact of nicotine vaping varies with age and sex
December 07, 2023

A new study on vapes led by Jibran Khokhar, PhD, challenges the belief that adolescents experience less severe withdrawal symptoms from nicotine than adults.
World AIDS Day: Decoding HIV’s stealth strategy
December 01, 2023

Virologist Stephen Barr, PhD, is on a mission to unveil and fight a ‘trickster’ HIV virus mechanism that evades the immune system.
World AIDS Day: Reflecting on a career of impact in probiotics research and community health
December 01, 2023

Professor Emeritus Gregor Reid, PhD, is being honoured with the creation of a new award - given out in his name - that recognizes his work in low- and middle-income countries through Western Heads East.
Announcement: Dr. Wael Haddara appointed as Interim Chair, Department of Medicine
December 01, 2023

We are pleased to announce that Dr. Wael Haddara has been appointed Chair/Physician Department Executive/Chief, Department of Medicine, Schulich School of Medicine & Dentistry, Western University and London Health Sciences Centre and St. Joseph's Health Care London.
Research shows men sleep better than women, sleep quality improves with age
November 29, 2023

Researchers at Schulich Medicine & Dentistry have unveiled crucial insights into the sleep health of middle-aged and older Canadians.
Promising AI research receives funding boost from Arthritis Society Canada
November 28, 2023

Researchers at Schulich Medicine & Dentistry are using artificial intelligence to improve care for patients with rheumatoid arthritis – with an eye to faster, more accurate diagnosis and personalized treatment.
Canada’s most powerful MRI system arrives at Schulich Medicine & Dentistry
November 23, 2023

The 15.2 Tesla pre-clinical scanner – only the second of its kind in North America and sixth in the world – enables researchers to study the brain with unprecedented resolution.
Resident alumna named to Canada’s 100 Most Powerful Women list
November 23, 2023

Dr. Sondos Zayed, resident alumna (Radiation Oncology), is being recognized for her leadership, vision and mentorship of others. The annual list is compiled by the Women’s Executive Network.
Professor's personal story leads to creation of 'guilt-free' luxury soap brand
November 21, 2023

Thyroid cancer diagnosis inspires Adjunct Professor Dr. Michelle Welch to co-found toxin-free luxury soap brand that reduces burden on the environment.
Western recruits top neuroimmunologist as Canada Excellence Research Chair
November 16, 2023

With $8 million in funding, Dr. Robyn Klein will set up Canada’s first-ever research program focused on studying the impact of infectious diseases, like COVID-19, on the brain.
Announcement: Dr. Frank Beier has been re-appointed as Chair, Department of Physiology and Pharmacology
November 16, 2023
I am pleased to announce Dr. Frank Beier has been re-appointed as Chair, Department of Physiology and Pharmacology, Schulich School of Medicine & Dentistry, Western University, effective July 1, 2024 to June 30, 2029.
Seinfeld provides insight into how our brains understand and appreciate humour
November 13, 2023

Neuroscientists at Schulich Medicine & Dentistry studied participants watching the classic TV series in an fMRI scanner. The results shed light on why patients with Parkinson’s disease might have difficulty understanding humour.
Research shows prenatal exposure to cannabis may increase diabetes risk in offspring
November 10, 2023

A study led by researchers at Schulich Medicine & Dentistry finds exposure to CBD impacts glucose intolerance in male rats.
Service to country and community inspired by medical career
November 09, 2023

Dr. Ian Ball is a Major in the Reserve Force of the Canadian Armed Forces and a member of the Office of Military Academic Medicine at Schulich Medicine & Dentistry. In the lead up to Remembrance Day, he shares his experiences, his inspiration to serve and advice for students.
Medical students’ initiative hopes to improve health-care services for Canadian refugees
November 07, 2023

A shared passion has led Class of 2024 medical students Lotus Alphonsus, Amalka De Silva and Penelope Neocleous to create a service that helps newcomers to Canada take control of their health-care needs.
Researchers chart new approach to improving kidney transplant access
November 03, 2023

A one-of-its-kind clinical trial to enhance access to kidney transplants in Ontario offers crucial insights for future strategies.
Recognizing exceptional service and contributions
November 01, 2023

Sixty-one faculty and staff members from Schulich Medicine & Dentistry were recently recognized with 25-Year Service Awards.
Announcement: Dr. James Calvin’s position as Chair/Physician Department Executive/Chief in the Department of Medicine has been extended
November 01, 2023
We are pleased to announce Dr. James Calvin has agreed to an extension as Chair/Physician Department Executive/Chief, Department of Medicine, Schulich School of Medicine & Dentistry, Western University and London Health Sciences Centre and St. Joseph's Health Care London.
Program brings together scientists and policymakers to improve communication, build relationships
October 27, 2023

How can we improve the flow of new knowledge from research into policymaking? Postdoctoral fellow Jonathan Michaels, PhD, took part in a program that brings scientists and policymakers together to break down stereotypes.
PhD graduate receives Governor General’s Gold Medal
October 25, 2023

Mariyan Jeyarajah, PhD’23, is among the recipients of this year’s Gold Medal, awarded for academic excellence at the graduate level.
AI-generated genetic guides improve CRISPR’s accuracy to target disease-causing superbugs
October 18, 2023

Schulich Medicine & Dentistry researchers have created a new CRISPR training tool that will help solve the problem of antimicrobial resistance, currently costing the health-care system $1.4 billion a year.
Announcement: Dr. Jorge Guillermo Burneo re-appointed as the Jack Cowin Chair in Epilepsy Research
October 18, 2023
I am pleased to announce Dr. Jorge Guillermo Burneo has been re-appointed as the Jack Cowin Chair in Epilepsy Research, Schulich School of Medicine & Dentistry, Western University effective November 1, 2023 to August 31, 2028.
Announcement: Dr. Patricia Hall appointed interim Chair of the Department of Psychiatry
October 18, 2023

We are pleased to announce that Dr. Patricia Hall has been appointed interim Chair of the Department of Psychiatry, Schulich School of Medicine & Dentistry, Western University, effective October 15, 2023 to January 14, 2024 or until a permanent Chair is appointed.
Diving into science and sport: Laura Muñoz Baena, PhD’23
October 18, 2023

As a national underwater hockey player, Laura Muñoz Baena draws on many of the same skills she’s developed during her PhD studies in bioinformatics and virus evolution.
Embracing challenge and change: Jeffrey Chong, MPH’23
October 17, 2023

For Jeffrey Chong, returning to school from the professional world meant stepping out of his comfort zone. The new graduate attributes much of his personal and professional growth to the Master of Public Health program.
Researchers reveal link between Alzheimer's disease and sex hormones
October 17, 2023

In a new study, researchers have shown female sex hormones play a significant role in how Alzheimer’s manifests in the brain.
Researchers investigate a new method of sedation for paediatric patients
October 16, 2023

Inhaled sedation could potentially improve long-term outcomes for paediatric patients.
A new classification of heart rhythm for stroke patients
October 13, 2023

A study led by Dr. Luciano Sposato finds atrial fibrillation detected after stroke seems more benign than pre-stroke irregular heartbeats.
Maternal diabetes impacts oxygen flow in umbilical cord, study suggests
October 13, 2023

A new study of high-risk pregnancies involving diabetes will help guide better care for mothers and babies at risk.
Food insecurity doubles rate of severe hypoglycemia in adults with diabetes: Study
October 12, 2023

The rising cost of living makes findings alarming for diabetes patients, says researcher Alexandria Ratzki-Leewing, PhD.
Announcement: Dr. Larry Jacobs re-appointed as Associate Dean, Windsor
October 06, 2023
We are pleased to announce that Dr. Larry Jacobs has been re-appointed as Associate Dean, Windsor in the Schulich School of Medicine & Dentistry, Western University, effective September 1, 2023 until August 31, 2028.
Expert Insight: COVID-19 and what to expect this fall
October 05, 2023

Though the global health emergency was declared over in May 2023, COVID-19 remains a major public health threat. Dr. Sameer Elsayed answers questions about COVID-19, new variants and vaccines.
Transforming medicine: Taylor Prize recipient harnesses the power of proteins to fight disease
October 05, 2023

Nabil G. Seidah is the recipient of the 2023 J. Allyn Taylor International Prize in Medicine awarded by Robarts Research Institute and Schulich Medicine & Dentistry. His work with a remarkable family of enzymes is leading to new biotherapies to combat disease.
War-torn homeland fuels dental student’s dreams for the future
October 03, 2023

Bohdan Semeliak, DDS Candidate 2025, is thousands of miles from his home in Ukraine, but the war that ravages his homeland has not deterred his dream of becoming a dentist.
Three researchers among new Canadian Academy of Health Sciences Fellows
September 27, 2023

Dr. Cindy Hutnik, Adrian Owen, PhD, and Dr. Carlos Quiñonez have been elected to the Canadian Academy of Health Sciences, recognizing their leadership, academic work and scientific creativity.
Pathology professor contributes to ‘sacred work’ of investigating missing Indigenous children
September 25, 2023

Forensic pathologist Dr. Rebekah Jacques is providing support and guidance to Indigenous families and communities as a member of the National Advisory Committee on Residential Schools Missing Children and Unmarked Burials.
Memories and milestones: A conversation with Dr. Hugh Allen, MD'48
September 21, 2023

It’s been 75 years since Dr. Hugh Allen, MD’48, was a medical student at Schulich Medicine & Dentistry. On the eve of Homecoming celebrations, the centenarian spoke with Omar Nawara, Medicine Class of 2026 and President of the Hippocratic Council, about his journey in medicine.
New Vanier scholar ‘living a dream’ at Schulich Medicine & Dentistry
September 19, 2023

Arriving in Canada as a 13-year-old refugee, Shahnaza Hamidullah has taken her love of education to the heights of academia as an MD/PhD candidate and Vanier scholar.
Research shows adolescent girls were severely affected by pandemic stress
September 19, 2023

A new study finds children’s visits to the ER for mental health concerns increased across Canada during the COVID-19 pandemic.
Scholars honoured by Royal Society
September 13, 2023

Three researchers at Schulich Medicine & Dentistry have been elected as new Fellows of the Royal Society of Canada in recognition of their outstanding scholarly and scientific achievements.
Researchers use AI to predict recovery after serious brain injury
September 11, 2023

Graduate students working with neuroscientist Adrian Owen, PhD, have developed a ground-breaking method for predicting which patients will survive a severe brain injury.
In major breakthrough, researchers close in on preeclampsia cure
September 08, 2023

Researchers from Schulich Medicine & Dentistry and Brown University have made groundbreaking progress towards identifying the root cause and potential therapy for preeclampsia – the leading cause of maternal death worldwide.
Announcement: Dr. Brant Inman appointed as the Chin-Hardie Chair in Urologic Oncology
September 06, 2023
Dr. Brant Inman has been appointed as the Chin-Hardie Chair in Urologic Oncology at the Schulich School of Medicine & Dentistry, Western University from September 15, 2023 – September 14, 2028.
New beginnings for the Dentistry Class of 2027
August 31, 2023

Schulich Medicine & Dentistry is welcoming 56 first-year dental students to the community. Meet three members of the Class of 2027 at the start of their journey in dentistry.
Four new Canada Research Chairs named at Schulich Medicine & Dentistry
August 29, 2023

From substance use to AI, new CRCs are addressing questions that will shape the future of humanity. Congratulations to Jibran Khokhar, PhD, Jennifer Guthrie, PhD, Pingzhao Hu, PhD, and Maria Mathews, PhD.
New beginnings for the Medicine Class of 2027
August 29, 2023

Schulich Medicine & Dentistry is welcoming the largest medical class in the School’s history. Meet four members of the Class of 2027 at the start of their journey in medicine.
MD/PhD candidates named Vanier scholars
August 29, 2023

Shahnaza Hamidullah and Edward Wang are being recognized for their leadership skills and scholarly achievement.
Record number of future doctors begin training at Schulich Medicine & Dentistry
August 29, 2023

The School is welcoming the largest medical class in its history, as 190 first-year students begin their training this week.
Commentary: The awful fires in the Northwest Territories light the way to a better, healthier future
August 28, 2023

In an opinion piece for The Globe and Mail, Nicole Redvers, PhD, and co-authors discuss how wildfires can point the way to climate-resilient health care.
Announcement: Dr. Richard Kim re-appointed as the Wolfe Medical Research Chair in Pharmacogenomics
August 28, 2023
The Office of the Dean is pleased to announce that Dr. Richard Kim was re-appointed as the Wolfe Medical Research Chair in Pharmacogenomics at the Schulich School of Medicine & Dentistry, Western University effective September 1, 2023, to August 31, 2028.
Multidisciplinary initiative to track influenza, other viruses in wastewater
August 24, 2023

The wastewater surveillance project, run jointly by Schulich Medicine & Dentistry and the Faculty of Engineering, has received new funding from the province to track COVID-19, influenza and other emerging viruses.
Medical student receives national award for community leadership and advocacy
August 23, 2023

As her home community in the Northwest Territories faces the dangers of wildfires, Laney Beaulieu is standing up for Indigenous and remote communities with hope for a better future. She is one of 17 medical students across Canada to receive the 2023 Canadian Medical Hall of Fame Award for Medical Students.
Consulting skills and public health enable master’s student to give back to the community
August 17, 2023

After 15 years in the working world, Jennifer Jones found a home in the School’s Master of Public Health program. She completed her practicum placement this summer in Yellowknife, working with the Office of Public Health.
Western signs nuclear research agreement with energy consultant Kinectrics
August 16, 2023

The partnership agreement focuses on health, energy, security and the environment. Collaborations include student training and internships, research and development activities, and knowledge mobilization.
$5.1 million donation boosts open hardware approach to motor neuroscience
August 15, 2023

A donation made by the Azrieli Foundation is taking an open-science concept to the next level, by enabling researchers across Canada to access and utilize electrodes developed and tested at Schulich Medicine & Dentistry and Emory University.
New study finds exercise, cognitive training combo boosts mental sharpness in seniors
August 14, 2023

Researchers found the effect of the combined intervention was larger than the individual effects of exercise or cognitive training alone. The study also found vitamin D supplements did not enhance cognition in seniors with mild impairment.
Seven interdisciplinary teams receive funding to solve research questions
August 10, 2023
Schulich Medicine & Dentistry researchers are hoping to unlock some of the major health challenges of our day, thanks to funding from the Collaborative Research Seed Grant (CRSG) program.
Study suggests cannabis use during pregnancy could cause lifelong cognitive deficits
August 03, 2023

Researchers also find impact of prenatal cannabis exposure on cognition and memory differs by sex.
Announcement: Dr. Shawn Steele appointed as Assistant Dean, Learner Experience (Dentistry)
August 03, 2023
Schulich Dentistry is pleased to announce that Dr. Shawn Steele has been appointed as Assistant Dean, Learner Experience (Dentistry), at the Schulich School of Medicine & Dentistry, Western University effective August 1, 2023, to July 31, 2028.
Collaboration is key for Frugal Biomedical Innovations program
August 02, 2023

Schulich Medicine & Dentistry is a key partner in Western’s Frugal Biomedical Innovations program, joining forces with Western Engineering. The program supports projects seeking to design, develop and deploy innovative medical technologies that improve health-care access for patients in remote and low-resource communities.
Announcement: Dr. Ali Tassi appointed Antonios Mamandras Chair in Graduate Orthodontics
August 01, 2023

The Office of the Dean is pleased to announce that Dr. Ali Tassi has been appointed as the Antonios Mamandras Chair in Graduate Orthodontics at the Schulich School of Medicine & Dentistry, Western University effective July 1, 2023 to June 30, 2028.
In memoriam: Dr. David Johnston
July 29, 2023
It is with immeasurable sadness that we announce the passing of Dr. David Wilson Johnston, who passed away on July 26, 2023.
Project grant recipients addressing critical gaps in health care
July 28, 2023

Researchers at Schulich Medicine & Dentistry have received more than $2.5 million in funding from the Canadian Institutes of Health Research through its latest project grants competition.
Commentary: The hidden curriculum and its impact on students and educators
July 27, 2023

In an opinion piece for University Affairs, Nicole Campbell, PhD, and Asil El Galad, BMSc'23, share experiences with the hidden curriculum and offer a framework for educators.
Funding fuels medical technology innovation for remote and low-resource communities
July 26, 2023

Nine research projects at Schulich Medicine & Dentistry have received catalyst grants through Western University’s newly established Frugal Biomedical Innovations program.
Study reveals link between food insecurity and mental health and substance issues in children
July 24, 2023

Children in Canada face uncertain access to adequate food, leading to more visits to an emergency room or hospitalization, says Schulich Medicine study.
Pioneering program opens doors to new opportunities for high-school students from diverse backgrounds
July 20, 2023

Through a new Schulich School of Medicine & Dentistry program designed to make biomedical sciences more accessible for students from diverse backgrounds, the trio are among the first group of local high-school students experiencing first-hand what their future in science could look like.
Schulich researchers discover molecule with promise to enhance vaccine efficacy
July 19, 2023

Findings have significant implications for strengthening the global response to current and future viral threats.
Medical Innovation Fellowship team creates adjustable socket to increase amputees’ comfort
July 14, 2023

Vessl Prosthetics founders Oleksiy Zaika and Sydney Robinson just clicked from day one, and now their startup is improving the quality of life for amputees
Researchers find potential in nerve block treatment for post-COVID smell distortions
July 12, 2023

Study offers crucial insights into post-COVID smell dysfunction, including a procedure reported to be most effective in treating this debilitating condition.
In Memoriam: Dr. Brian Burke
July 10, 2023
It is with immeasurable sadness that we announce the passing of Dr. Brian Burke, who passed away on July 6, 2023
Fecal transplants show promise in improving melanoma treatment
July 07, 2023

Using a technique pioneered by a Schulich Medicine researcher, a world-first clinical trial has found fecal microbiota transplants (FMT) are safe and show promise in improving response to immunotherapy in patients with advanced melanoma.
Announcement: Dr. Alison Allan, re-appointed as Chair, Anatomy & Cell Biology
July 07, 2023
The Office of the Dean is pleased to announce that Dr. Alison Allan has been re-appointed as Chair, Anatomy & Cell Biology, Schulich School of Medicine & Dentistry, Western University effective July 1, 2023, until June 30, 2028.
Announcement: Dr. Reena Khanna, Assistant Dean, Clinical Research Training
July 06, 2023
The Office of the Dean is pleased to announce that Dr. Reena Khanna has been appointed as the Assistant Dean, Clinical Research Training at the Schulich School of Medicine & Dentistry, Western University effective July 1, 2023, to June 30, 2028.
Announcement: Dr. Cheryle Séguin, Acting Chair, Physiology and Pharmacology
July 05, 2023
The Office of the Dean is pleased to announce that Dr. Cheryle Séguin, has been appointed as Acting Chair, Physiology and Pharmacology, Schulich School of Medicine & Dentistry, Western University effective July 1, 2023, until June 30, 2024.
New insights lead to a better understanding of long COVID
July 03, 2023

Using advanced research techniques, including a form of artificial intelligence, researchers have discovered unique patterns of blood plasma proteins in patients with suspected long COVID that could help improve outcomes.
Research into Canada’s most common inherited condition has made diagnosis easier
June 28, 2023

Decades of work by researchers like Schulich Medicine’s Dr. Paul Adams have lessened the challenges of diagnosing haemochromatosis, Canada’s most common inherited condition.
Afghan scholar faces Taliban threats in pursuit of freedom
June 21, 2023

When the return of the Taliban made life and liberty impossible in Afghanistan, Dr. Nasar Ahmad Shayan and his family made their way to Schulich Medicine. Now he continues his studies, bringing a unique perspective to the School.
BMSc grad combines science and sports to change the narrative on equity
June 21, 2023

As a former Mustang and newly-minted BMSc grad, Jessica Brown is using her many experiences to be an advocate for change on campus and in the community.
Sitara Lewis graduates with a passion to advocate for those experiencing homelessness
June 20, 2023

A defining lesson in empathy while at Schulich Medicine has shaped the career of this BMSc graduate. Find out more in this Q&A.
Shaping futures, one smile at a time: Kate Jacques’ journey to becoming a dentist
June 19, 2023

Kate Jacques gained a love of dentistry early on as a dental assistant. Now her passion to help those underserved has brought her full circle as she graduates today from Schulich’s Doctor of Dental Surgery program.
Passion meets purpose: How Fabio Salerno served on the frontlines of COVID-19 while pursuing a PhD
June 16, 2023

Dr. Fabio Salerno faced a life-changing dilemma: Pursue his PhD at Schulich Medicine or return to his home in Italy to help that COVID-ravaged country. Find out more about his career journey and the decisions he made in this Q&A.
Announcement: Dr. Sumit Agrawal reappointed as Interim Chair, Department of Otolaryngology
June 16, 2023
The Office of the Dean is pleased to announce that Dr. Sumit Agrawal has been re-appointed to the Department of Otolaryngology as Interim Chair effective July 1, 2023 to December 31, 2023.
New study investigates how probiotics can improve outcomes in knee replacement surgeries
June 15, 2023

Research teams focuses on how a healthy gut biome – a core aspect of our health – can improve surgical outcomes
Announcement: Dr. John Fuller re-appointed as Interim Chair, Department of Anesthesia & Perioperative Medicine
June 15, 2023
The Office of the Dean is pleased to announce that Dr. John Fuller has been re-appointed in the Department of Anesthesia & Perioperative Medicine as Interim Chair.
Announcement: Drs. Robert Teasell and Keith Sequeira re-appointed as interim leadership of the Department of Physical Medicine & Rehabilitation
June 15, 2023
The Office of the Dean is pleased to announce that Dr. Robert Teasell and Dr. Keith Sequeira have been re-appointed in the Department of Physical Medicine & Rehabilitation as Interim Chair and Interim Physician Executive & Interim Chief respectively. The reappointments are effective July 1, 2023 to December 31, 2023, or until permanent appointments have been made.
Announcement: Dr. Michael Ott appointed in the Department of Oncology as Chair
June 14, 2023

The Office of the Dean is pleased to announce that Dr. Michael Ott has been appointed in the Department of Oncology as Chair effective June 1, 2023 to May 31, 2028.
Announcement: Dr. Craig Campbell appointed as Chair, Department of Paediatrics
June 14, 2023
The Office of the Dean is pleased to announce that Dr. Craig Campbell has been appointed in the Department of Paediatrics as Chair effective June 1, 2023 to May 31, 2028.
New study using nuclear medicine and rare isotopes in the fight against cancer
June 13, 2023

Study uses specially designed molecules that work like a homing device to deliver radioactive isotopes to cancer cells.
Bridging the gap: Jelena Poleksic integrates history and medicine as first MD+ grad
June 08, 2023

Jelena Poleksic is the first graduate of Schulich Medicine’s MD+ program, a new track that offers many options for medical students looking for new learning opportunities. As you’ll see, it’s a perfect fit for Poleksic.
Researcher’s new online platform demonstrates the power of physical activity in chronic disease management
June 08, 2023

Founded by Dr. Jane Thornton, the activity platform provides tailored exercises for those living with chronic health conditions, demonstrating the transformative power of physical activity.
From student leader to valedictorian: Hailey Guertin's journey of impact and achievement
June 07, 2023

With a passion for medicine and a commitment to her community, Hailey Guertin graduates from the MD program today as the first valedictorian from the Windsor campus. It’s just one of many honours for this outstanding student.
A microscope that makes diagnosing malaria easier and cheaper
June 02, 2023

A student team from Western, including Justin Yang, a Bachelor of Medical Sciences graduate at Schulich Medicine & Dentistry, is taking their malaria diagnostic innovation into the finals of the World’s Challenge Challenge.
Annual Awards of Excellence ceremony brings Schulich Medicine & Dentistry community together
June 01, 2023

Schulich School of Medicine & Dentistry recognized the exceptional faculty and staff, distinguished by their leadership skills and embodiment of the values of the School.
Research reveals physician payment methods influence health-care delivery and ED visits
May 30, 2023

Study sheds light on impact of fee-for-service and capitation methods of physician payment on health services in Ontario.
Announcement: Dr. Cindy Hutnik named the Marcel and Louise Brunette Research Chair in Ophthalmology
May 29, 2023

The Office of the Dean is pleased to announce that Dr. Cindy Hutnik, Chair/Chief of the Department of Ophthalmology, has been named the inaugural Marcel and Louise Brunette Research Chair in Ophthalmology.
Fardowsa Abdullah Halane: Personal experiences fuel the drive for change
May 26, 2023

Fardowsa Abdullah Halane brings a passion for change to her time in the Master of Public Health Program at Schulich Medicine. Find out more about her journey.
Announcement: Dr. Andrew House named Clark Chair in Nephrology
May 26, 2023
The Schulich School of Medicine & Dentistry is pleased to announce that the leader of our Nephrology division, Dr. Andrew House, has been named the inaugural William F. Clark Chair in Nephrology.
Schulich Medicine researchers fast-tracking drug development process among four recipients to receive grants
May 24, 2023

A project to fast-track drug development for neurodegenerative diseases by a team of researchers at Schulich Medicine & Dentistry was one of two Western projects among four across Canada awarded grants through the Canada Brain Research Fund (CBRF).
Family medicine residents join alliance to improve health of those experiencing homelessness in Windsor
May 18, 2023

The Shelter Health & Social Medicine Family Medicine residency elective at Windsor campus promises to bridge this health-care gap and enrich learning experience for medical trainees
Discovery Week: 25 years of life and practice in regional Ontario
May 18, 2023

For 25 years, medical students at Schulich Medicine have “discovered” what medical practice in regional Ontario has to offer through Discovery Week – a program that is also bringing hope to the physician shortage in southwestern Ontario.
Schulich Medicine & Dentistry joins historic pledge to preserve planetary health
May 17, 2023

Academic health institutions, including medical schools in Canada, are agreeing while caring for human health is a priority, it’s equally important to “do no harm” to the health of the planet.
Schulich Medicine researchers shed light on symptoms of understudied spine disease
May 17, 2023

Cheryle Séguin and team examine the association between pain and DISH, a disease that causes calcification of the spine, and open the door to treatment.
Learner perspectives: Teaching provides surprising opportunities to learn
May 12, 2023

The student-run Teaching in Medicine Club connected with Canadian Association of Medical Education award winners Dr. James Ross and Dr. Laura Foxcroft to find out about their insights into effective teaching.
Announcement: Dr. Victor Ng appointed as the Assistant Dean, Distributed Education
May 11, 2023

The Undergraduate Medical Education Office is pleased to announce that Dr. Victor Ng has been appointed as the Assistant Dean, Distributed Education, at the Schulich School of Medicine & Dentistry, Western University effective May 1, 2023 to April 30, 2028.
Announcement: Dr. Laura Diachun appointed as Assistant Dean, Learner Experience
May 08, 2023

Dr. Laura Diachun has been appointed as the Assistant Dean, Learner Experience (Postgraduate), at the Schulich School of Medicine & Dentistry, Western University effective May 1, 2023 to April 30, 2028.
Announcement: Dr. Ruth Lanius re-appointed as the Harris Woodman Endowed Chair in Psyche and Soma
May 08, 2023

The Office of the Dean is pleased to announce that Dr. Ruth Lanius has been re-appointed as the Harris-Woodman Endowed Chair in Psyche and Soma at the Schulich School of Medicine & Dentistry, Western University from April 1, 2023 – March 31, 2028.
Schulich Medicine to expand medical school training with additional educational and residency spots
May 04, 2023

Ontario bolsters Schulich School of Medicine & Dentistry’s efforts to tackle physician shortage in region.
Abdifatah Fiqo: Changing careers for the better
May 03, 2023

After working for 10 years, Abdifatah Fiqo brought his desire to help a broader audience to the Master of Public Health Program. And he’s never looked back.
The face of hope: Schulich Medicine fellow restores lives in war-torn Ukraine
May 03, 2023

Dr. Ivanka Nebor and a team of U.S. surgeons and nurses travelled to Ukraine to perform critical reconstructive surgeries on patients wounded by war
Schulich Medicine professor earns Distinguished University Professor honour
May 02, 2023

Lorelei Lingard, Centre for Education Research & Innovation, plus Shawn Whitehead and Andrew Pruszynski recognized for academic achievements.
In Memoriam: Dr. Arthur Kidd
May 02, 2023

It is with heavy hearts that we announce the passing of Dr. Arthur (Art) Kidd, who passed away on April 24, 2023 at the age of 75.
Western establishes pioneering $4M endowed chair for urologic cancer research
April 27, 2023

Chin-Hardie Chair in Urologic Oncology bolsters Western’s leadership in developing life-saving interventions for cancers of the bladder, kidney and prostate.
Windsor Campus recognizes its shining stars at gala awards event
April 27, 2023

Schulich School of Medicine & Dentistry recognized the exceptional faculty, residents, staff, and learners who have made its Windsor Campus a critical part of the health care fabric of the Windsor-Essex region.
Western to revolutionize drug development for brain diseases with $24M federal funding boost
April 26, 2023

First-of-its-kind platform will fast track drug development and help identify effective new therapies within six years.
Study aiming to slow cognitive decline in older adults gets $1.5M boost
April 25, 2023

The first large-scale Canadian clinical trial using personalized lifestyle intervention to help older adults with mild cognitive impairment is getting underway with support from a Weston Foundation grant.
Announcement: Dr. Alice Tsui appointed as the Assistant Dean, Undergraduate Medical Education – Windsor Campus
April 21, 2023

The Office of the Dean is pleased to announce that Dr. Alice Tsui has been appointed as the Assistant Dean, Undergraduate Medical Education - Windsor Campus at the Schulich School of Medicine & Dentistry, Western University, effective April 1, 2023 to March 31, 2028.
2023 Alumni of Distinction Award recipients
April 20, 2023

The 2023 Alumni of Distinction Award recipients are international leaders, accomplished scholars, community advocates and trailblazers in their fields.
Space medicine career launched at Schulich comes full circle with alumni award
April 20, 2023

Dr. Kris Lehnhardt turned a love of space into a career at NASA. Here the alumni award recipient recounts his journey from childhood dream to designing the medical systems that will take us to the Moon and beyond.
A vision for the future of ICES Western: A Q&A with Dr. Kristin Clemens
April 19, 2023

Dr. Kristin Clemens is the new Site Director for ICES Western. In this Q&A, she discusses the impact of the work being done through ICES Western and her hopes for the future.
From acute to chronic, David Seminowicz is researching the problem of pain
April 18, 2023

David Seminowicz, PhD, is researching how the brain responds to pain. His work is leading to new solutions that could help with acute and chronic pain management.
Western researchers join the call for rational discourse to protect vital virus research
April 17, 2023

Virology researchers say vital virus research that helped mitigate the pandemic's impact is now under ill-informed scrutiny and may hinder efforts to prepare humanity for future health threats.
Thriving on discovery: A Q&A with Robert Bartha, vice dean, Research & Innovation
April 12, 2023

Research is entering a new and exciting period of growth, says Robert Bartha, vice dean, Research & Innovation. Find out more about his plans for raising research at Schulich Medicine.
Study validates new biopsy method for breast cancer patients
April 06, 2023

Lawson researchers find that a new biopsy method may be a more accurate and comfortable option for patients.
Announcement: 2023 Awards of Excellence - Windsor Campus Recipients
April 06, 2023
The Awards of Excellence – Windsor Campus celebrate the commitment and dedication of faculty, staff and learners. The recipients are being recognized for their leadership, dedication and their support of their colleagues across the School.
Announcement: Celebrating the 2023 Awards of Excellence recipients
April 06, 2023
The 2023 Awards of Excellence recipients enrich life and learning at Schulich Medicine & Dentistry each and every day. Their commitment to the School’s mission, their innovative approaches to their work, and their leadership distinguish them. It is with great pride that we recognize and honour their achievements.
Study reveals alarming trend in nicotine vaping among high school students
April 04, 2023

More than a quarter of Canadian high school students reported vaping in the previous month, and 12 per cent have exclusively smoked vapes containing nicotine, study says.
New $3.5M endowed chair establishes Schulich Medicine as a kidney research powerhouse
March 31, 2023

The William F. Clark Chair in Nephrology - named in honour of Dr. William F. Clark, professor emeritus at Schulich Medicine & Dentistry - will help attract and retain top talent, and enhance life-saving research .
Expert Insight: An FAQ on avian flu
March 30, 2023

Avian influenza is a highly contagious viral infection that affects wild and domestic birds worldwide. Schulich Medicine’s Dr. Sameer Elsayed answers questions about the bird flu and its emergence as a public-health threat.
Obehi Ikem, ITD 2025: Solving the mystery of service
March 28, 2023

Growing up in Nigeria, Obehi Ikem was intrigued by the passion of the health-care professionals who took care of her grandfather. Now her dentistry training has given her new insight into this passion for caring.
Schulich prof develops AI-powered bedside lung ultrasound
March 27, 2023

New investor funding will enable Deep Breathe to expand research and development as it inches closer to market launch
Student, charity founder, UN rep: Western gives wings to Kenisha Arora
March 22, 2023

With a focus on building a better world, the third-year medical sciences student at Schulich Medicine & Dentistry looks to spread hope at home and abroad.
Windsor Campus celebrates 15 years of impact in region
March 21, 2023

It has been 15 years since the first students walked through the doors of Schulich Medicine & Dentistry’s Windsor Campus. Take a look at the impact the School has had on Windsor and region – through the stories of those who have been there.
Study finds co-infection with ‘superbug’ bacteria increases SARS-CoV-2 replication
March 20, 2023

Study identifies a common protein from the Staphylococcus aureus bacteria boosts SARS-CoV-2 replication up to 15 times, making the COVID-19 outcome even more deadly.
New study shows technology could play an important role in mental health support
March 15, 2023

Smart home monitoring systems may assist those living with both mental health and physical disorders.
Western project finds VR gives viewers front-row seat experience
March 14, 2023

A 360-degree camera set-up and VR technology could revolutionize sports viewing, a study by Paul Frewen, a professor in psychiatry at Schulich Medicine, suggests.
Building a Black community of support a key part of MD student’s journey
March 13, 2023

Gelila Alemayheu, a second-year student in the MD program, and her fellow students are part of a growing Black community at Schulich Medicine & Dentistry
Schulich Medicine part of new Canada research hub for pandemic preparedness
March 09, 2023

Schulich Medicine & Dentistry is a partner in the Canadian Hub for Health Intelligence and Innovation in Infectious Diseases (HI3), created to support the development of life-saving therapeutics that target infectious diseases.
Study reveals need for remote dental care during COVID-19
March 07, 2023

The survey of over 450 dental professionals in Ontario showed approximately 50 per cent of dentists in Ontario used some form of teledentistry to provide remote care during pandemic.
Team calls for better physician licensing system to address medical care in Space
March 03, 2023

With the increase in Space travel, one question facing the global community is around the rules and laws that govern Space, including who can practise medicine in the final frontier.
Adventurers retrace trek of gold-seeking trio featuring Western medicine school co-founder
March 02, 2023

Before becoming a prominent Canadian psychiatrist, and co-founder of Western’s medical school, Dr. Richard Maurice Bucke was the sole survivor of a gold-seeking expedition through the Sierra Nevada mountains.
CIHR transitions in care funding
February 27, 2023

Two Western researchers are looking to improve health care for Canadians experiencing transitions in care with support from a CIHR funding boost.
Study explores link between neighbourhoods and heart health
February 24, 2023

New research looks at national health data, community well-being and neighbourhood information to study effects of social environment on cardiovascular health
Bringing Indigenous stories to the table in environmental health policy
February 23, 2023

Gerald McKinley, PhD, will spend a year in the U.S. as a Harkness Fellow. He will study methodologies to bring Indigenous voices to the development of environmental health policy.
In Memoriam: Dr. Tutis Vilis
February 22, 2023

It is with great sadness we share that Dr. Tutis Vilis – Professor Emeritus at Schulich School of Medicine & Dentistry – has passed away.
Learning how our brain’s rewards systems work
February 21, 2023

With cutting-edge technology, Miguel Skirzewski and fellow researchers are learning how our brain’s rewards systems work, and gaining insights into new treatments for neuropsychiatric disease.
Empowering careers through an immersive African experience
February 17, 2023

Learn about the amazing experiences students had in Africa as part of the Global Skills Opportunity and the Queen Elizabeth Scholars program.
Honouring the legacy of Western’s first Black medical graduate
February 16, 2023

Dr. Lewis H. Milburn lived both his dreams, to serve in the military and be a doctor, inspiring future generations
New partnership advances research in health, clean energy
February 15, 2023

Agreement with Canadian Nuclear Laboratories and Atomic Energy of Canada Limited includes imaging and radiopharmaceuticals
Fellowship drives innovation in solving patient challenges
February 14, 2023

Medical Innovation Fellowship brings together entrepreneurial talents to fill the gaps in patient care.
Researchers receive nearly $9-million in CIHR funding to tackle urgent health challenges
February 09, 2023

Canadian Institutes for Health Research funding boon highlights the exceptional quality of research being done at Schulich Medicine & Dentistry.
Faculty and learners honoured with education awards
February 08, 2023

The Canadian Association for Medical Education honoured Schulich Medicine & Dentistry faculty and learners with awards to recognize their contributions to medical education.
Dentistry Community Clinic
February 07, 2023

A partnership with Schulich School of Medicine & Dentistry has helped Oxford County Community Health Centre’s dental clinic expand its dental services to address the unmet treatment needs of Oxford County residents.
Expert Opinion: Cuts to telehealth reduces access to gender-affirming care
February 03, 2023

This piece in the Conversation, co-written by Greta Bauer, PhD, an adjunct professor in Epidemiology and Biostatistics at Schulich Medicine, looks at how cuts to telehealth are reducing access to care for trans and non-binary people.
Dr. Alan Gob recognized for innovative quality improvement curriculum delivery
January 27, 2023

Dr. Alan Gob has channeled his enthusiasm for self-improvement into developing innovative methods of curriculum delivery that are changing the way QI principles are taught.
New 3D ultrasound may improve accuracy of liver cancer treatment
January 25, 2023

A simulated study by Schulich Medicine and Lawson Health Research Institute researchers has found a new robotic ultrasound system can optimize liver cancer ablation therapy.
Announcement: Dr. J Don Richardson appointed as the Tanna Schulich Chair in Neuroscience & Mental Health
January 25, 2023

The Office of the Dean is pleased to announce that Dr. J Don Richardson has been appointed as the Tanna Schulich Chair in Neuroscience & Mental Health at the Schulich School of Medicine & Dentistry, Western University, effective February 1, 2023 to January 31, 2028.
Announcement: Drs. Jefferson Frisbee and Narinder Paul named the Ting-Yim Lee Chairs
January 24, 2023

The Office of the Dean is pleased to announce that Dr. Jefferson Frisbee is the Ting-Yim Lee Chair in Medical Biophysics and Dr. Narinder Paul is the Ting-Yim Lee Chair in Translational Medical Imaging at Schulich School of Medicine & Dentistry.
Researcher examines new connections in helping implant patients
January 24, 2023

Thanks to an award from Arthritis Society Canada, Matthew Teeter, PhD, and his team will combine medical imaging and biological research to find new ways to improve implant-bone healing.
Study shows virtual care removed barriers for patients during pandemic
January 23, 2023

While the pandemic shifted primary health care from in-person to virtual care, family physicians continued to deliver a high standard of care for patients, according to research led by Schulich Medicine’s Bridget Ryan, PhD.
In Memoriam: Dr. Brian Flumerfelt
January 23, 2023

It is with great sadness we share that Dr. Brian Flumerfelt – Professor Emeritus at Schulich School of Medicine & Dentistry – has passed away.
Associate Dean receives significant funding to make clinical trials more efficient
January 19, 2023

A Schulich School of Medicine & Dentistry Associate Dean’s mission to make it easier and more efficient to conduct clinical trials received a funding boon today, with Dr. Amit Garg at the centre of two major grants announced by the Canadian Institutes of Health Research (CIHR).
Expert Opinion: A FAQ on COVID-19 subvariant XBB.1.5
January 18, 2023

In this piece in the Conversation, Schulich Medicine & Dentistry's Dr. Sameer Elsayed addresses frequently asked questions about the COVID-19 subvariant XBB.1.5, nicknamed ''Kraken.'
Peer support program now available for physicians at Windsor campus
January 16, 2023

Peers for Peers provides one-on-one support for physicians suffering the mental and emotional stresses of a high workload. Now the program has rolled out to Schulich Medicine & Dentistry’s Windsor campus.
Research team develops new open-source app for precise brain mapping
January 12, 2023

Professor Ali Khan and former PhD student Jordan DeKraker and team have developed a web-based tool that uses artificial intelligence to iron out the complex hippocampus
From baseball stars to hockey goalies – it’s all in the hips
January 12, 2023

Robarts Scientist Geoffrey Ng, supported by an Arthritis Society Canada Ignite Innovation Grant, is using a state-of-the-art robot and medical imaging to help improve hip surgeries.
Schulich Medicine research leads to new understanding of how HIV hides itself in the body
January 10, 2023

A new joint study led by Stephen Barr at Schulich Medicine and University of Ottawa’s Marc-André Langlois could help lead to more effective HIV therapies.
Building the dental school of the future
January 09, 2023

With a new leader and a renewed mission to be of service to its patients, Dentistry is moving forward with new energy at Schulich School of Medicine & Dentistry.
Robarts scientists combine unique talents to help patients
January 05, 2023

Recruited to Robarts and Schulich’s Department of Medicine for their specialized skillset, two scientists join forces to target therapies for complex heart disease and critically ill patients.
